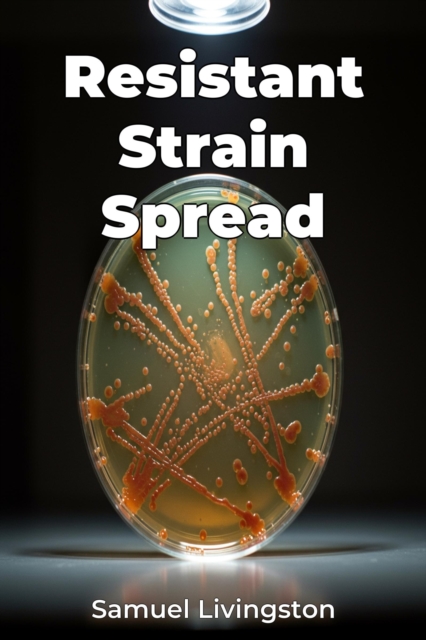
Resistant Strain Spread

Resistant Strain Spread
Resistant Strain Spread explores the urgent global threat of antibiotic resistance, detailing how bacteria evolve and share resistance genes.
The book investigates both the biological mechanisms, like horizontal gene transfer via transposons, and the epidemiological factors driving the spread of resistant strains.
A key insight is that antibiotic resistance isn''t just a biological issue but a com...
Resistant Strain Spread explores the urgent global threat of antibiotic resistance, detailing how bacteria evolve and share resistance genes.
The book investigates both the biological mechanisms, like horizontal gene transfer via transposons, and the epidemiological factors driving the spread of resistant strains.
A key insight is that antibiotic resistance isn''t just a biological issue but a com...
